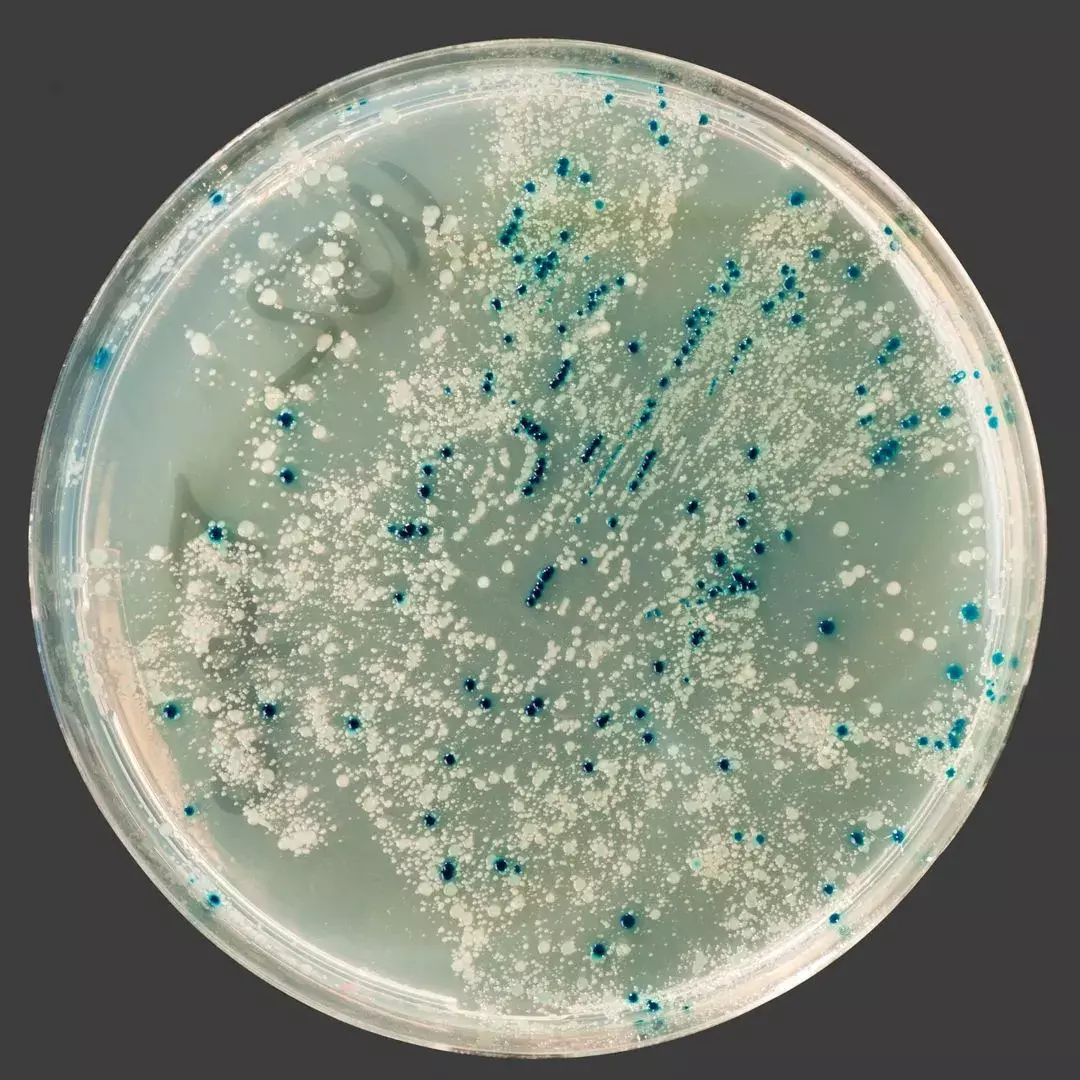

Professional Mold Testing & Inspection Services
Stop wondering. Start knowing. Professional testing & inspections that reveal the complete truth about mold in your home. We'll help you to understand:
- ✅ Do I have mold? 99.9% lab-verified accuracy
- ✅ Where is it? Find all hidden mold in your home
- ✅ Why is it here? Detailed root cause analysis
- ✅ How soon? Results in 24-48 hours
- ✅ Next steps? Expert inspection, zero obligation
Eliminated severe mold from our entire house in just 6 hours. No mess, no toxic fumes, and our children stayed home safely. Two years later, still completely mold-free.



We had a tricky situation and they dealt with it quickly and professionally, and all for less cost than alternative options and hardly and intrusion on our home and life.


Accredited & Certified

.png)


Why Mold Testing Matters...
Most homeowners don't realize they have a mold problem until health issues appear or visible growth spreads. By then, it's already costly and potentially dangerous.
Most mold grows in places you'll never see, inside walls, under floors, in HVAC ducts & behind appliances.
You might smell it. You might feel the symptoms. But without professional testing, you're left guessing about:
- 😕 What's actually in your air (and if it's making you sick)
- 🧐 Where the mold is hiding (and how extensive the problem is)
- 🤨 Why you have mold (and how to stop it from returning)
- 😧 How much it will cost to fix (and if you're covered by insurance)
Guesswork leads to wasted money on wrong solutions, continued health problems, and mold that keeps coming back.


The Solution Is Simpler Than You Think.
Mold inspections & testing gives you definitive answers in just 24-48 hours. Know exactly what you're dealing with, understand the root cause and get a clear plan to eliminate it permanently.
No More Guesswork. Get Clear Answers About Your Mold Problem
From discovery to elimination, we handle every step of solving your mold problems with proven solutions.
Know What You're Breathing

Professional air quality analysis by accredited laboratories reveals exactly what mold is present, how severe it is & if it's a health risk.
- ✅ Specific mold species identification
- ✅ Spore count measurements (per m³)
- ✅ Severity assessment with lab report
- ✅ Results in 24-48 hours
Understand Why You Have Mold

Comprehensive on-site assessment using thermal imaging and diagnostic tools to identify moisture sources and root causes.
- ✅ Thermal imaging and moisture detection
- ✅ Visual inspection + photo documentation
- ✅ Root cause analysis
- ✅ Expert recommendations and action plan
Eliminate Mold Permanently

Our patented dry fog technology eradicates mold in 4-12 hours, no demolition, no toxic chemicals, with a 12-month warranty.
- ✅ 99.99% mold elimination
- ✅ Non-toxic, family-safe treatment
- ✅ Complete in hours, not weeks
- ✅ 12-month warranty included

Not All Mold Tests Are The Same. We'll Help You Decide.
Different situations require different testing approaches. Here's how to choose the right one for your home.

"I think I have mold but can't see it"
Measures what's floating in your air, living & dead mold spores, counts per cubic meter, and species identification. The gold standard for detecting hidden mold contamination.
"I see mold and need to know what it is"
We take direct samples from visible growth, cultures them in a lab, and identifies the exact species. No guessing about what you're looking at.

"I need the most complete analysis possible"
Uses advanced DNA technology to profile all mold in your home and compare it to national averages. The most thorough option available.


Still Unsure Which Test You Need?
Every home and situation is different. Call us for a free consultation, we'll discuss your symptoms, concerns & budget to recommend the most effective testing approach for your specific needs.

What You'll Learn From Your Expert Inspection
Start with a complimentary inspection. Our certified technicians assess your property & provide expert guidance, with no obligation for further treatment.
Is this mold dangerous, or just ugly? Find out if what you're seeing poses health risks or is simply cosmetic, and what immediate action (if any) is required.
Where is moisture hiding that I can't see? Discover hidden water sources feeding mold growth before they cause thousands in structural damage.
Why does mold keep coming back in my home? Uncover the root cause, not just the symptoms, so you can eliminate mold permanently.
Am I wasting money on testing I don't actually need? Get expert guidance on whether lab testing is necessary or if your situation is clear enough to move directly to treatment
What's this going to cost me to fix? Receive honest, transparent pricing with detailed documentation. Know exactly what you're facing before you commit to anything.
See the Transformation: Real Homes, Real Results
Project photos from actual customers who got their healthy homes back in hours, not weeks.


We got quotes for $15,000+ involving weeks of wall removal and rebuilding. Pure Maintenance solved the same problem in 7 hours for a fraction of the cost. The before and after photos speak for themselves. A complete transformation without touching a single wall.


The speed was incredible. Our daughter has asthma and we needed a solution fast. They eliminated severe mold throughout our home in just 6 hours, and we returned home immediately. What would have taken other companies weeks of demolition was done in a single day. Our air quality tests proved it worked perfectly.



The mold in our bathroom and bedroom was so severe we thought we'd need to gut the entire upstairs. Pure Maintenance treated our whole house in 8 hours. No mess, no demolition, and we were home the same day. Six months later, not a trace of mold anywhere. Worth every penny!


The Only True Mold Specialists in the USA
While others treat mold as a side service, we've dedicated everything to perfecting mold elimination with technology no one else can offer.

Save on demolition & reconstruction. Traditional methods take weeks of tearing out walls and rebuilding. We treat entire homes in 4-12 hours with zero damage.

The chemicals we use are on the EPA's Safer Chemicals Ingredients List. Our patented treatment is family and pet friendly. We're NOT replacing harmful mold with harmful chemicals.

The only company confident enough to guarantee results. If mold returns within 12 months, we return for free. Our confidence in permanent results is unmatched.

Revolutionary dry fog that competitors can't access. We hold exclusive rights to the world's most advanced mold elimination system. What we do isn't available anywhere else.

Every technician is MICRO accredited. This is the industry's highest mold certification. This specialized training means accurate diagnosis, proper treatment, and permanent solutions.

No two mold problems are identical. We customize every treatment based on your home's specific conditions, mold severity, and root causes – ensuring full elimination.

Meet Nevada's Leading Mold Specialists
A dedicated team of certified professionals protecting families and homes across Nevada.



The Mold Specialists You Can Trust
Pure Air Nevada has exclusive access to patented dry fog technology that's revolutionizing how mold is eliminated in American homes. Our singular focus on mold remediation means we've invested everything into perfecting this one critical service and ensuring every technician is trained to the highest standards.
Our revolutionary approach has been validated by the US Army Corps of Engineers through rigorous 6-month testing. We've helped thousands of American families reclaim their homes from mold. Restoring not just air quality, but peace of mind.
Why People Are Choosing Us
🏠 Health-First Approach - Your family's safety comes before everything. We use only EPA-registered ingredients from the Safer Chemical List – never toxic solutions.
🔬 Scientific Excellence - Our technology has been tested and validated by military standards, ensuring expert diagnosis and treatment every time.
💯 Guaranteed Results - We stand behind our work with a 12-month guarantee because we know our technology works.
🤝 Transparency & Trust - Independent lab testing and clear communication mean you'll always know exactly what's happening in your home.


100s of Five-Star Reviews From Mold-Free Homeowners


Timely and effective service. We had a great experience with them from start to finish. Very friendly and helpful staff, and the service they performed has already made a world of difference in my overall physical health.



I’m beyond impressed. It’s was shortly after I moved into my new condo that I smelled the most horrific smell in my bathroom. Your guys came out, and since then I’ve had absolutely no problem with smell. I am so grateful!



Their "dry fog" treatment was amazing, it got rid of everything. I worked with Jeremy, he was always on time, communicated through the entire process and always made sure we were taken care of. Absolutely excellent.

Ready to Eliminate Your Mold Problem for Good?
Get your no obligation quote and free phone consultation to discover how we can restore your home's health in just one day.
Our certified technician conducts a thorough property survey with air quality testing and answers all your questions on-site.

During the same visit, we collect samples for laboratory analysis to identify specific mold species, spore counts, and contamination severity.

Receive your detailed report with expert interpretation, root cause analysis, and transparent recommendations for next steps.

